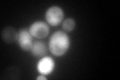
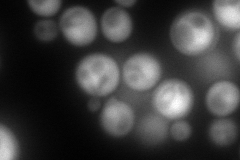

View description
Phospholipid-binding protein; expression is induced by osmotic stress
Localization:
Intensity:
Fold change:
Significance:
-
C’ GFP library in SD
cytosol35.42 -
N' NOP1pr-GFP in SD
cytosol328.291 -
N' TEF2pr-mCherry in SD

nucleus0 -
N' NATIVEpr-GFP in SD

cytosol61.8377 -
N' TEF2pr-VC and Cyto-VN in SD

cytosol78.0832 -
C’ GFP library in SD+DTT

cytosol37.761.06No -
C’ GFP library in SD+H2O2

cytosol19.530.55No -
C’ GFP library in Starvation Media

cytosol51.961.46Yes -
C’ GFP library on the background of Pup2-DaMP

cytosol -
C’ GFP library on the background of CCT mutant

cytosolN/AN/ANo
